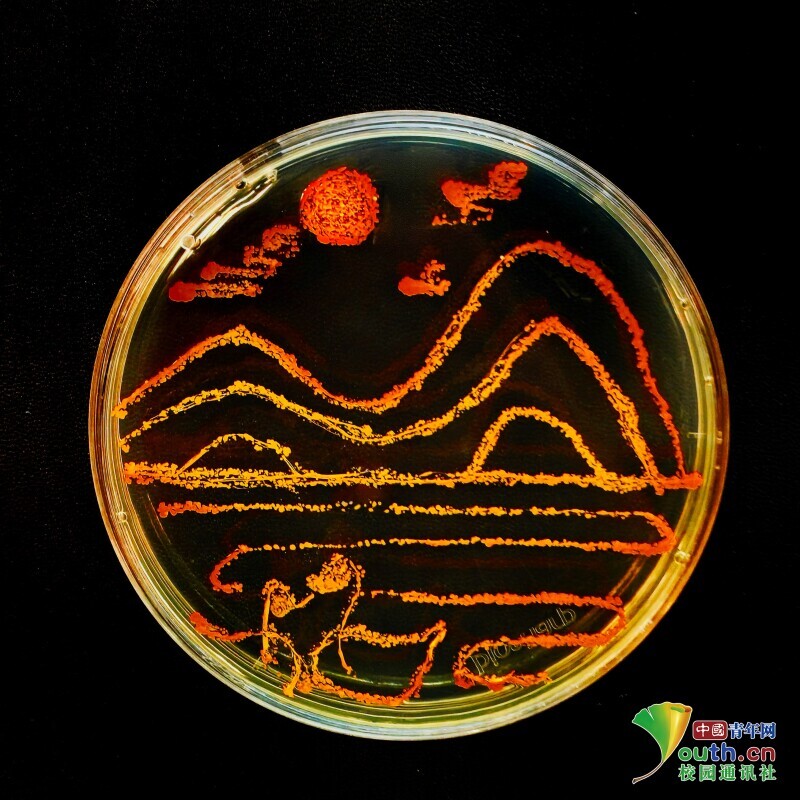

【中青校园11月16日】临近校庆,江南大学生物工程学院的同学们以培养皿为画布,以接种环为画笔,用不同微生物作颜料,进行了一场创意菌落绘画,庆祝江南大学建校65周年。毕赤酵母、大肠杆菌、酿酒酵母……各式各样的菌种经微生物分离、培养等操作后“跃然纸上”,成为色彩丰富的“颜料”。方寸之间,同学们用自己的方式让微生物鲜活了起来,为江南大学献上最诚挚的生日祝福。

图为江南大学庆祝65周年校庆标识菌落画。中国青年网通讯员 黄润仪 摄

图为江南大学校徽菌落画。中国青年网通讯员 解修兵 摄

图为江南大学“小鼋”卡通形象菌落画。中国青年网通讯员 张亚茹 摄

图为江南大学校园风光菌落画。中国青年网通讯员 解修兵 摄

图为“江南大学 生日快乐”字样菌落画。中国青年网通讯员 张亚茹 摄

图为江南大学与“65周年”元素菌落画。中国青年网通讯员 管杏子 摄
图为江南大学校园风光菌落画。中国青年网通讯员 宋敏霞 摄
本文来源于:中青校园
原文链接:https://xiaoyuan.cycnet.com.cn/s?signature=ZbDm0KxOyWQGgYNjrBV4jMJ9DF8lqo1oLpzq253Av968kJPEMd&uid=1539474&phone_code=a4288d863646ad21f474f8a9750a652b&scid=1607542&time=1700122282&app_version=(null)&sign=70617758b56a8a71c5cad1af5c33f3fc#
